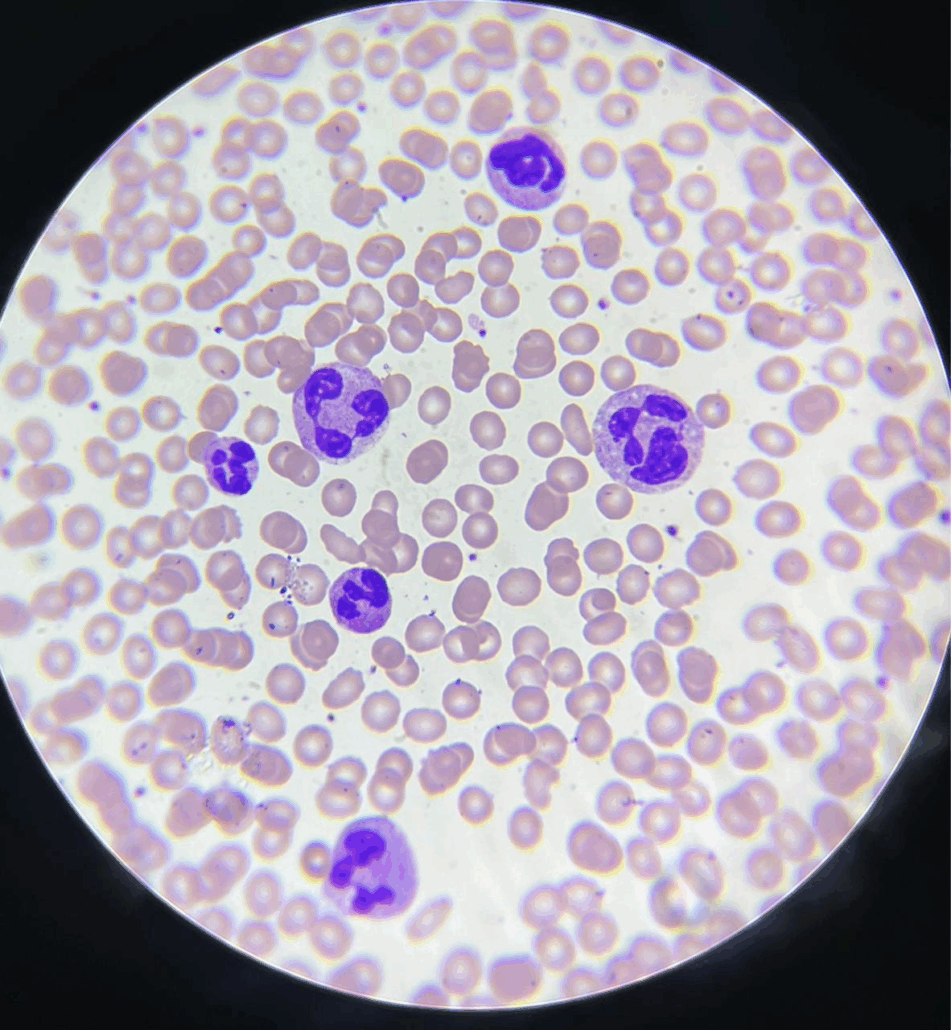

Ao analisar um esfregaço sanguíneo, muitas vezes nos deparamos com desafios que exigem um olhar atento. Entre eles, está a diferenciação entre neutrófilos normais e os chamados neutrófilos gigantes (displásicos). Essa distinção é fundamental porque, embora em alguns casos possa parecer apenas uma variação de tamanho, em outros pode indicar alterações medulares significativas, especialmente em doenças hematológicas graves. Portanto, compreender as diferenças morfológicas e clínicas entre essas células é essencial para a prática laboratorial.
Neutrófilos normais
Em primeiro lugar, é importante entender o que caracteriza um neutrófilo normal. Normalmente, essas células apresentam um tamanho apenas ligeiramente maior que o de um linfócito pequeno, mantendo sempre uma proporção estável em relação aos eritrócitos do campo. Além disso, o núcleo costuma ser multilobulado, geralmente com 3 a 4 lóbulos, bem delimitados e com cromatina condensada. Já o citoplasma é moderado e exibe granulações discretas e regulares.
Neutrófilos gigantes: quais são os sinais distintivos
Em contrapartida, quando observamos um neutrófilo gigante, o que chama a atenção de imediato é o aumento desproporcional do tamanho celular. Nesse caso, a célula ocupa muito mais espaço em comparação com os eritrócitos adjacentes. Além disso, o núcleo aparece volumoso, com lóbulos espessos ou irregulares. Paralelamente, o citoplasma se mostra mais amplo, podendo exibir hipogranulação.
💡 Dica prática: ao comparar com os eritrócitos vizinhos, se o neutrófilo parecer demasiadamente grande, há indícios de gigantismo.
Paciente apresentando gigantismo em neutrófilos
Doenças e contextos em que aparecem
Esse achado é fortemente associado às neoplasias mielodisplásicas (NMDs), refletindo uma displasia na granulopoese. Além disso, ele também pode estar presente em leucemias mieloides, seja na fase inicial da doença, seja durante sua evolução. Paralelamente, em situações de regeneração medular intensa, como após quimioterapia ou diante de infecções graves, a medula óssea pode acelerar a produção celular, resultando na presença de neutrófilos gigantes. Em menor escala, esse fenômeno também pode ocorrer em outros quadros displásicos menos comuns.
Conclusão
Em síntese, a diferenciação entre neutrófilos normais e gigantes vai muito além de um simples detalhe morfológico. Trata-se de um achado que, quando corretamente reconhecido, pode direcionar a investigação para alterações hematológicas relevantes, especialmente em doenças displásicas e neoplásicas. Portanto, o trabalho criterioso no microscópio, associado ao contexto clínico e laboratorial do paciente, continua sendo uma ferramenta indispensável para o diagnóstico preciso.
IMPORTÂNCIA DA CAPACITAÇÃO PARA PROFISSIONAIS DA ÁREA LABORATORIAL
Se você busca aprofundar seus conhecimentos sobre anisocitose e outras condições hematológicas, bem como aprimorar suas habilidades analíticas, investir em uma pós-graduação é uma excelente opção.
A Pós-graduação em Hematologia Laboratorial e Clínica foi desenvolvida para profissionais que desejam se destacar no mercado, com um conteúdo atualizado, bem como voltado para a prática da rotina laboratorial. Ademais, oferecemos aulas 100% online e ao vivo, com flexibilidade para você estudar onde e quando quiser.
Com uma metodologia que integra teoria e prática, o curso proporciona uma imersão completa na rotina laboratorial, preparando você para ser uma referência no campo da hematologia.
Toque no botão abaixo e conheça a pós-graduação em Hematologia Laboratorial e Clínica.
Referências:
- Bain, B. J. Blood Cells: A Practical Guide. 5th ed. Wiley-Blackwell, 2015.
- Rodak, B. F., Carr, J. H. Hematology: Clinical Principles and Applications. 6th ed. Elsevier, 2020.
- McPherson, R. A., Pincus, M. R. Henry’s Clinical Diagnosis and Management by Laboratory Methods. 24th ed. Elsevier, 2021.

